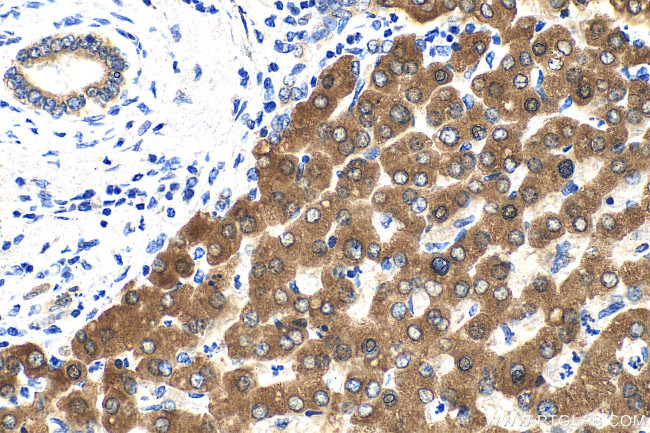
PON3 Antibody in Immunohistochemistry (Paraffin) (IHC (P))

Search
Proteintech
PON3 Polyclonal Antibody
{{$productOrderCtrl.translations['antibody.pdp.commerceCard.promotion.promotions']}}
{{$productOrderCtrl.translations['antibody.pdp.commerceCard.promotion.viewpromo']}}
{{$productOrderCtrl.translations['antibody.pdp.commerceCard.promotion.promocode']}}: {{promo.promoCode}} {{promo.promoTitle}} {{promo.promoDescription}}. {{$productOrderCtrl.translations['antibody.pdp.commerceCard.promotion.learnmore']}}
产品信息
31793-1-AP
种属反应
宿主/亚型
分类
类型
抗原
偶联物
形式
浓度
规格
纯化类型
保存液
内含物
保存条件
运输条件
产品详细信息
Immunogen sequence: AFRERVNASR EVEPVEPENC HLIEELESGS EDIDILPSGL AFISSGLKYP GMPNFAPDEP GKIFLMDLNE QNPRAQALEI SGGFDKELFN PHGISIFIDK DNTVYLYVVN HPHMKSTVEI FKFEEQQRSL VYLKTIKHEL LKSVN
靶标信息
Paraoxonase-1 (PON1) is a calcium-dependent ester hydrolase that is tightly associated with apoA-I in HDL. PON1 prevents the oxidation of LDL, thereby the formation of atherogenic oxidised-LDL. Polymorphisms of the human PON1 gene are correlated with coronary artery disease, indicating a genetic association between PON1 and coronary artery disease. PON1 activity is lower in subjects prone to development of atherosclerosis such as in type 1 and type 2 diabetes, familial hypercholesterolemia, and renal disease, indicating the involvement of PON1 in atherosclerosis development. PON2 is a ubiquitously expressed intracellular protein that can protect cells against oxidative damage. PON3 is similar to PON1 in activity but differs from it in substrate specificity. PON1 and PON3 are implicated in lowering the risk of developing coronary artery disease and atherosclerosis. Human PON3 protein shares the 3 conserved cysteine residues identified in PON1, suggesting their importance of in vivo activities. PON1-based catalytic scavengers can be a way to safe and effective organophosphate intoxication.
仅用于科研。不用于诊断过程。未经明确授权不得转售。
篇参考文献 (0)
生物信息学
蛋白别名: arylesterase 3; lactonase; paraoxanase-3; Serum paraoxonase/lactonase 3; unnamed protein product
基因别名: 2810004E20; AI786302; PON3
UniProt ID: (Human) Q15166, (Rat) Q68FP2, (Mouse) Q62087
Entrez Gene ID: (Human) 5446, (Rat) 312086, (Mouse) 269823